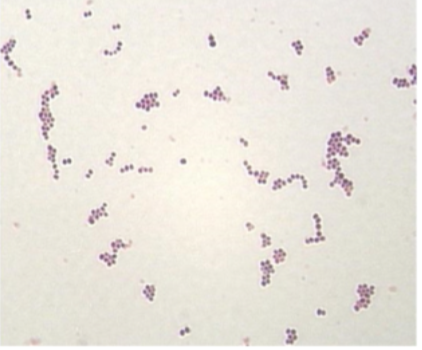
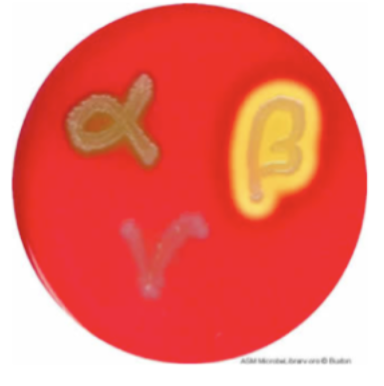
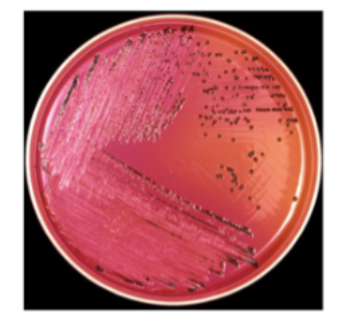
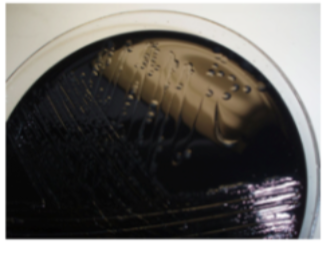
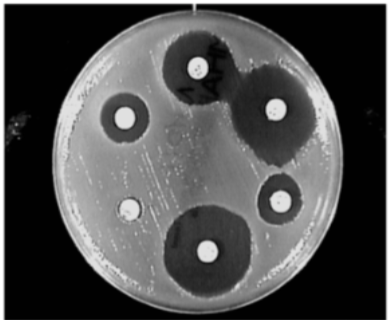

Why are bacterial cultures used?
Bacterial cultures are used to figure out which antibiotic to use (you can test antimicrobial resistance)
what technique is used to look at resistence genes and which is good to look at for infection response?
•Serologyis a good way of looking at the body’s response to infectionoE.g. chicken pox -‐you can do a set of blood before or at the start of the infection and another set in 10 days or so to see whether they have gone from IgG negative to IgG positive -‐this shows that you’ve had an immunological response to chicken pox oSometimes this is used if you can’t culture the organism e.g. syphilis•
Molecular Techniquesare rapid and sensitive but there is a myriad of resistance genes so these are not good for routine useoIt is useful with MRSA because the resistance mechanism is encoded by the MecA gene -‐so if you do PCR for this gene you will know that it is resistan
what is antibiotic susceptibility testing?
Antimicrobial Susceptibility Testing-‐usually this is done by phenotypic methods -‐you impregnate agar with a microorganism and put antibiotic discs on it
What is the significance of gram stain ?
This helps with selecting antibiotics because Gram positives are susceptible to certain antibiotics and Gram negatives are susceptible to others and they tend to cause different types of infection
where is gram positive and gram negative found usually?
- Gram POSITIVE= skin and soft tissue
- Gram NEGATIVE= abdomen and urinary tract
when do you give patients antibiotics immediately before sending cultures ?
MENINGITIS or MENINGOCOCCAL SEPTICAEMIA
What is the difference between gram positive and gram negative?
•Gram POSITIVEhas a thicker peptidoglycan cell wallwhich holds theGram stain and stains PURPLE•Gram NEGATIVEhas an outer membraneoutside the cell wall which stops them from taking up the stain oInstead they take up the counter-‐stainand stain PINK•Many antibiotics target the cell wallbut these antibiotics may not be able to get past the outer membrane of the Gram negative bacteria and hence will be ineffective on Gram negatives

How do gram positive cocci divide and how do they look?
- This is useful initial information to guide antibiotic treatment
- The most common bacteria you find are Gram Positive Cocci
- Staphylococci have a very particular pattern of dividing where they divide in two and then the daughter cells divide again to form a clump of four
- These clumps look like a bunch of grapes
- Streptococci divide end on end and form chains
how can staphylococci be further subdivided into and what type of infections do these cause?
- Out of the staphylococci, you have coagulase positive and coagulase negative staphylococci
- Coagulase POSITIVE= STAPHYLOCOCCUS AUREUS(the most important of coagulase positive staphylococci)
- Coagulase is a virulence factorwhich helps Staphylococcus aureus to cause infection
- Coagulase NEGATIVE= common skin microbes oThese don’t tend to cause infection unless there are some opportunistic circumstances (e.g. central lines, prosthetic joints)
- In most cases, coagulase negative bacteria found in a blood culture are probably contaminants from taking the blood
what type of infections does staphylococcus aureus and coagulase negative staphylococci cause?

How can gram positive cocci look ?
- In chaiins
- in clumps
how are streptococci divided into depending on how they look o agar?
Alpha Haemolysis:
- INCOMPLETE haemolysis
- This turns the agar a GREEN colour
Beta Haemolysis
- COMPLETE haemolysis
- This CLEARS the agar
Give examples of alpha and beta heamolytic streptococci?
Alpha Haemolytic
- StreptococcioStreptococcus pneumoniae-‐common cause of pneumonia and meningitis
Beta Haemolytic Streptococci
Group A Streptococcus:
- Streptococcus pyogenes
- Causes skinand soft tissueinfections (e.g. necrotising fasciitis)
- Also causes rheumatic fever and scarlet fever
Group B Streptococcus
- Streptococcus agalactiae
- Important cause of sepsis in young children(neonatal septicaemia)
- Also involved in infections in diabetics(they are susceptible to group B streptococcal infection)
how does gram negative bacilli look and why?
- These do NOT take up the Gram stain and instead take up the counter stain making it appear pink
- These are E. coli-‐they are short and fat

What 3 bacteria are stools commonly tested for and what do these cause?
Fauces are full of bacteria
- Salmonella
- Shigella
- Campylobacter
- cholera
- c.difficle
- e.coli
These are common causes of diarrhoea in the UK
How is C,difficle tested for?
- C. difficilegot its name because it is difficult to growso labs tend to use detection of their toxin or the toxin gene as the marker for C. difficile
- We use a combination of antigen and toxin gene PCR to diagnose C. difficile
how does the agar plate look with salmonella on XLD agar?
•XLD = xylose lysine deoxycholate •The salmonella goes this colour because salmonella CANNOT ferment xylose•Most other coliforms or enteric bacteria can ferment xylose so it goes a yellow colour•The salmonella also forms hydrogen sulfidewhich forms BLACK colonies•So this agar is very specificfor salmonella
how long does campylobacter take to grow?
•Campylobacter takes quite a long time to grow (48 hours) •Campylobacter is able to survive at 42 degrees•So, you incubate the sample at 42 degrees to kill the other bacteria in the stool sample •Then you put the remaining campylobacter on a selective agar dish
What does PPV stand for and what does it depend on and why does this matter?
Positive predictive value depends on the pre‐test probability of the sample being positive
- The more likely a patient is to have a disease (i.e. based on their clinical history), the more likely a positive test represents a true positive
- If the patient is very unlikely to have the disease and you send it for a test, the lower the positive predictive value
- KEY POINT: don’t just test everybody for everything, send tests for the things that you think it is most likely to be
How is MIC used clinically?
Minimum Inhibitory Concentration (MIC)= the lowest amount of antibiotic required to inhibit the growth of bacteria in vitro
•People set breakpointswhich correlate MIC with clinical success when using the antibiotic•If the bacteria has an MIC below the breakpointthen there is a good correlation with clinical successif you use that antibiotic•If the bacteria has an MIC that is ABOVE the breakpointthen it should be reported as resistant•Most labs use graded MIC strips to measure MIC (we did this in a practical last year)
How is antibiotic sensitivity tested and what is an advantage of this?
Disc diffusion:
This method also allows you to do multiple antibiotics very quickly
are carbapenemase treateable?
Carbapenemase(type of beta lactamase) -‐breaks down ALLclasses of beta lactams so theyare resistant to pretty much everything and are almost untreatable


